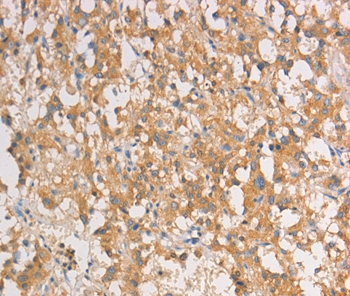

ART3 Antibody (APC)
LS-C512612
ApplicationsWestern Blot
Product group Antibodies
TargetART3
Overview
- SupplierLifeSpan BioSciences
- Product NameART3 Antibody (APC)
- Delivery Days Customer23
- ApplicationsWestern Blot
- Applications SupplierWB
- CertificationResearch Use Only
- ClonalityPolyclonal
- ConjugateAPC (Allophycocyanin)
- Estimated Purity...
- Gene ID419
- Target nameART3
- Target descriptionADP-ribosyltransferase 3 (inactive)
- Target synonymsADP-ribosyltransferase C2 and C3 toxin-like 3; ARTC3; ecto-ADP-ribosyltransferase 3; mono(ADP-ribosyl)transferase 3; mono-ADP-ribosyltransferase; NAD(P)(+)--arginine ADP-ribosyltransferase 3
- HostRabbit
- IsotypeIgG
- Storage Instruction2°C to 8°C
- UNSPSC12352203